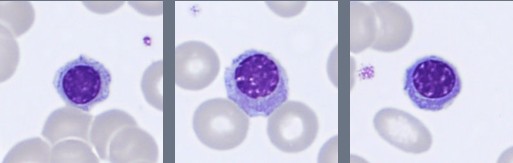
Monthly Cell Challenge #3 2026 NRBC
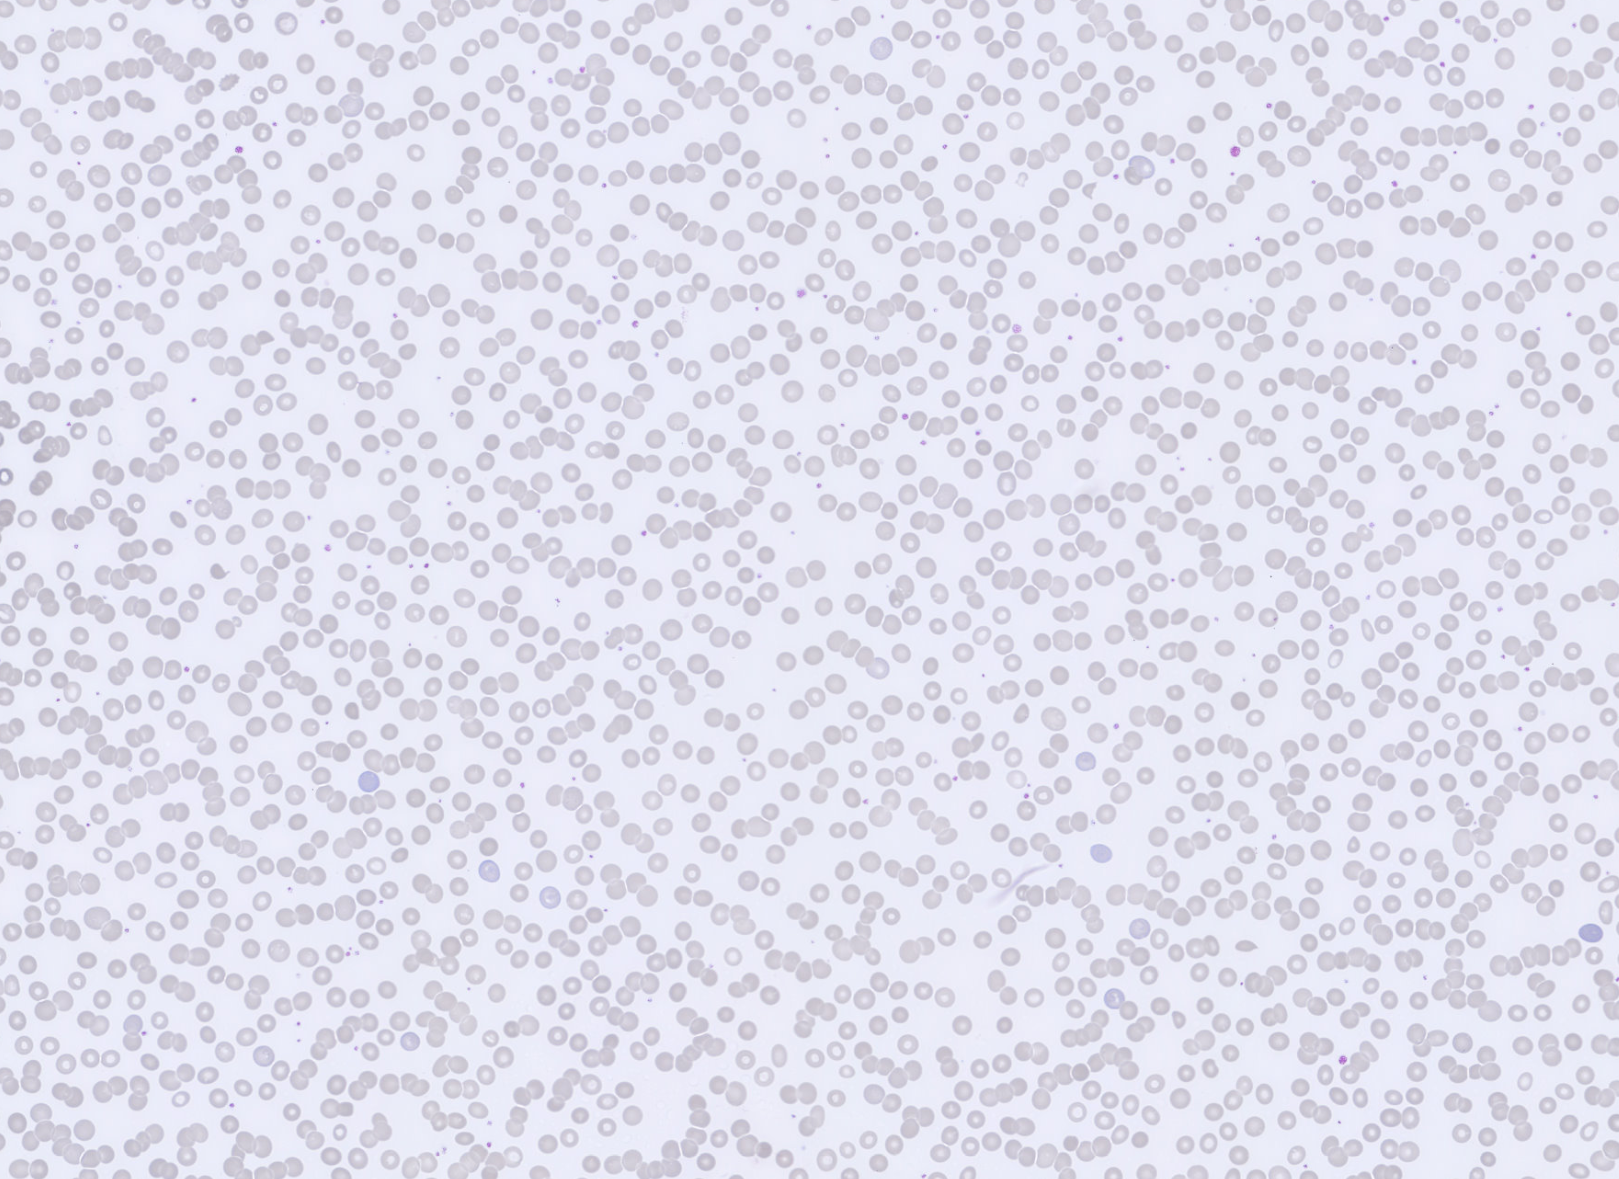
Monthly Cell Challenge #3 2026 RBC overview
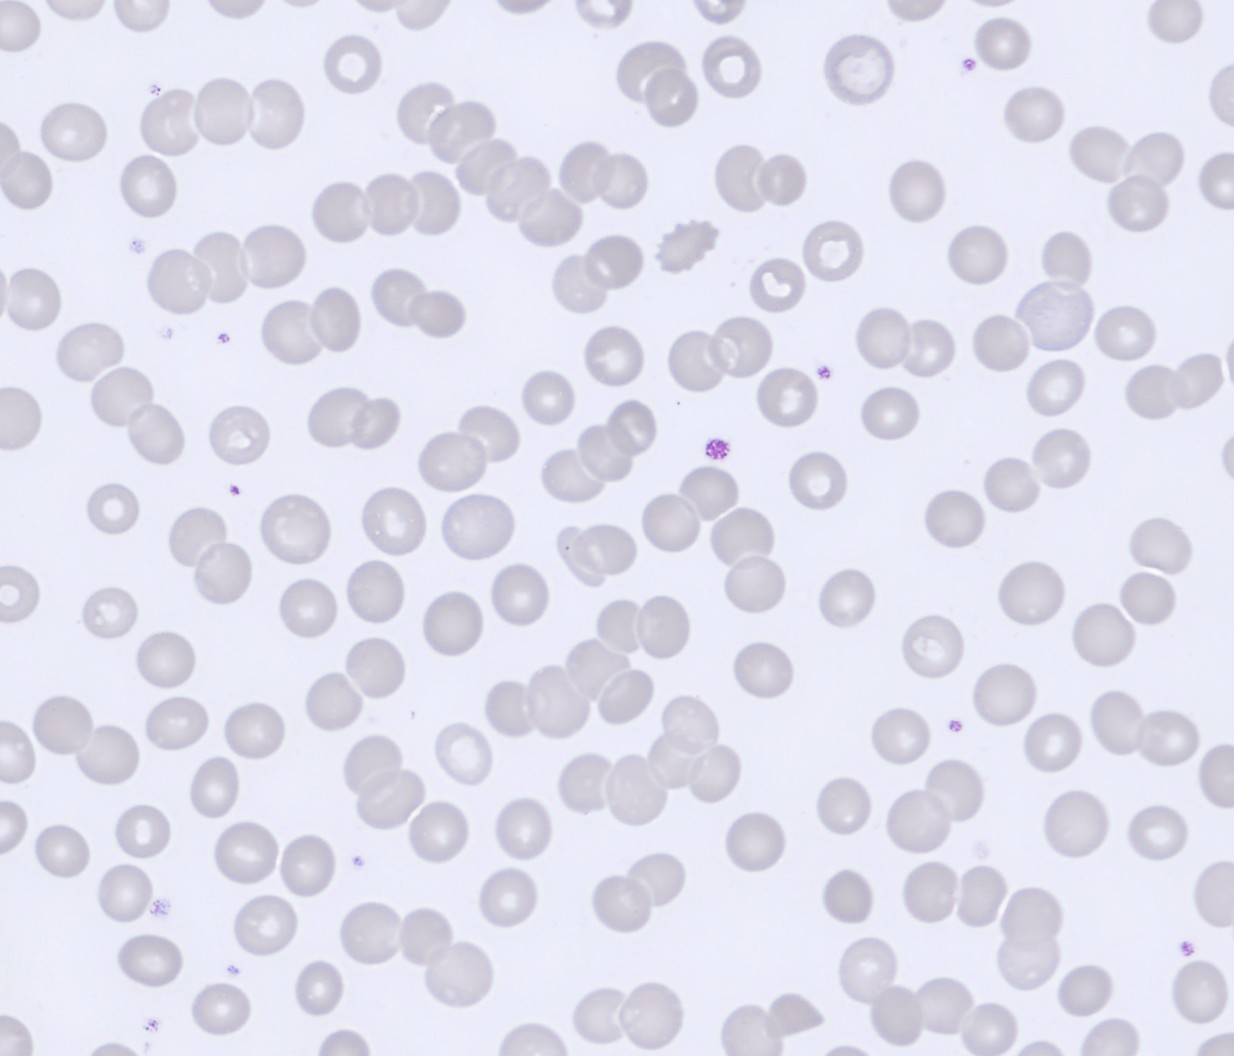
Monthly Cell Challenge #3 2026 RBC overview zoom

Monthly Cell Challenge #03 / 2026

Following the Clues from Blood to Bone Marrow
A 67-year-old woman was referred for hematological evaluation due to increasing fatigue and reduced physical capacity over several months. She reported generalized weakness but denied fever, infections, or significant weight loss. No recent travel or acute illness was reported.
Physical examination revealed a slightly pale but otherwise stable patient. No significant lymphadenopathy was detected. Mild skeletal discomfort had been noted intermittently but was not considered severe by the patient.
Initial laboratory investigations showed abnormalities in the peripheral blood smear, prompting further morphological evaluation and bone marrow examination.
CBC results:
| Test | Result | Units |
|---|---|---|
| WBC | 3.6 | x109/L |
| RBC | 3.2 | 1012/L |
| HGB | 93 | g/L |
| MCV | 92 | fL |
| PLT | 174 | x109/L |
Blood smear analysis classification on CellaVision DC-1
| WBC Differential | % | x109/L |
|---|---|---|
| Band | 8.5 | 0.3 |
| Neutrophils | 63.5 | 2.3 |
| Lymphocytes | 15 | 0.5 |
| Monocytes | 6.5 | 0.2 |
| Myelocytes | 0.5 | 0.0 |
| Metamyelocytes | 0.5 | 0.0 |
| Blasts | 0.5 | 0.0 |
| Plasma cell | 5 | 0.3 |
Blood smear findings:

Segmented neutrophils with 2–4 nuclear lobes are present, and some cells show toxic granulation. Lymphocytes are predominantly small to medium-sized with condensed chromatin and scant cytoplasm, while monocytes appear as larger cells with gray-blue cytoplasm and irregular nuclei. A population of circulating plasma cells is observed, characterized by eccentric nuclei, coarse chromatin, and basophilic cytoplasm with a perinuclear clearing. Occasional nucleated red blood cells (NRBC) are also present.

The erythrocytes are predominantly normocytic and normochromic with relatively uniform morphology. No significant anisocytosis or poikilocytosis is observed. Prominent rouleaux formation is present, with erythrocytes arranged in linear stacks in multiple areas of the smear.
The presence of circulating plasma cells prompted further investigation with a bone marrow aspirate, which was subsequently examined using the CellaVision® Bone Marrow Aspirate Applicationon the CellaVision® DC-1 system.

When reviewing the differential area images of the CellaVision® Bone Marrow Aspirate Application, an increased population of plasma cells is already evident. Review of the differential demonstrates a marked expansion of plasma cells, representing approximately 65% of the nucleated cells.
The plasma cells show typical morphology with an eccentric nucleus, coarse chromatin, and moderate to abundant basophilic cytoplasm. Many cells display a clear area next to the nucleus corresponding to the Golgi region. Some variation in cell size and cytoplasmic amount is observed.
Residual hematopoiesis is present but relatively reduced, with erythropoiesis and myelopoiesis represented by smaller proportions of cells.

Flow cytometric analysis of the bone marrow demonstrates a distinct plasma cell population representing approximately 61% of nucleated cells with lambda light chain restriction. These plasma cells do not express CD56. A polyclonal B-cell population is present, and T cells show normal expression of CD3/CD5 and CD4/CD8. No increase in CD34-positive cells is detected.
Diagnosis:
Plasma cell myeloma / Multiple myeloma (PCM/MM)
Discussion:
Plasma cells are differentiated B lymphocytes that produce immunoglobulins. They are normally present in low numbers in bone marrow and lymphoid tissues and are rarely seen in peripheral blood. Therefore, the presence of circulating plasma cells should prompt further evaluation for possible underlying pathological conditions, including plasma cell neoplasms [1,2].
Plasma cell neoplasms are a group of clonal B-cell disorders characterized by the accumulation of abnormal plasma cells, most commonly in the bone marrow. Morphologically, plasma cells typically show an eccentric nucleus, condensed “clock-face” chromatin, and basophilic cytoplasm. A clear area next to the nucleus, corresponding to the Golgi apparatus, is often visible. Extensive infiltration of plasma cells in the bone marrow may suppress normal hematopoiesis and contribute to anemia and other cytopenias. [1,2].
In the present case, the increase in plasma cells observed in both the peripheral blood and bone marrow raised suspicion of an underlying plasma cell disorder. Multiple myeloma is the most common plasma cell neoplasm and accounts for approximately 1% of all cancers and about 10% of hematologic malignancies. The disease mainly affects older adults, with a median age at diagnosis of around 65–70 years. Clinical manifestations often result from bone marrow infiltration and increased production of monoclonal immunoglobulins, and may include anemia, bone pain, renal impairment, hypercalcemia, and an increased susceptibility to infections [3,4].
According to the diagnostic criteria established by the International Myeloma Working Group (IMWG), multiple myeloma is defined by the presence of ≥10% clonal plasma cells in the bone marrow or a biopsy-proven plasmacytoma, together with one or more myeloma-defining events. These include evidence of end-organ damage, known as the CRAB criteria (hypercalcemia, renal insufficiency, anemia, or bone lesions), or specific biomarkers associated with a high risk of disease progression. Importantly, ≥60% clonal plasma cells in the bone marrow is itself considered a myeloma-defining biomarker, even in the absence of clinical end-organ damage [4,5].
Immunophenotyping plays an important role in confirming clonality and characterizing neoplastic plasma cells. These cells typically show strong expression of CD38 and CD138 and demonstrate light-chain restriction, indicating monoclonality. Additional markers such as CD56, CD117, CD200, or CD28 may also be expressed. In the present case, flow cytometry demonstrated a lambda-restricted plasma cell population, confirming a clonal plasma cell proliferation [2,5].
An interesting feature in this case is the absence of CD56 expression on the plasma cells. CD56 is expressed in many cases of multiple myeloma and is involved in the adhesion of plasma cells to the bone marrow microenvironment. Reduced or absent CD56 expression has been associated with more aggressive disease features and may be seen in cases with circulating plasma cells [2,6].
Treatment of multiple myeloma has improved considerably over the past two decades. Current therapies often include combinations of proteasome inhibitors, immunomodulatory drugs, corticosteroids, and monoclonal antibodies, particularly those targeting CD38. In eligible patients, autologous stem cell transplantation followed by maintenance therapy remains an important part of first-line treatment. Although multiple myeloma is generally considered incurable, modern therapies have significantly improved survival and long-term disease control [4,5].
This case highlights the importance of careful morphological review of peripheral blood smears, as circulating plasma cells may provide an important clue to an underlying plasma cell disorder. CellaVision® digital morphology systems support systematic cell review and allow laboratories to analyze both peripheral blood and bone marrow specimens. Extending digital morphology from peripheral blood to bone marrow evaluation will help laboratories identify abnormal cell populations more efficiently and further strengthen the role of morphology in routine hematology diagnostics.
References:
[1] Bain BJ. Blood Cells: A Practical Guide. 6th ed. Oxford: Wiley-Blackwell; 2020.
[2] Rodak BF, Fritsma GA, Keohane EM. Rodak’s Hematology: Clinical Principles and Applications. 6th ed. Elsevier; 2020.
[3] WHO Classification of Tumours Editorial Board. WHO Classification of Tumours of Haematolymphoid Tumours. 5th ed. IARC; 2024.
[4] Rajkumar SV. Multiple myeloma: 2024 update on diagnosis, risk-stratification and management. American Journal of Hematology.
[5] Rajkumar SV et al. International Myeloma Working Group updated criteria for the diagnosis of multiple myeloma and related plasma cell disorders. Lancet Oncology.
[6] He H, Li W, Wu D, et al. Prognostic significance of CD56 expression in multiple myeloma: a meta-analysis. Acta Haematol. 2022;145(2):123-132. doi:10.1159/000518345. Available from: https://www.tandfonline.com/doi/pdf/10.1080/16078454.2021.2019365